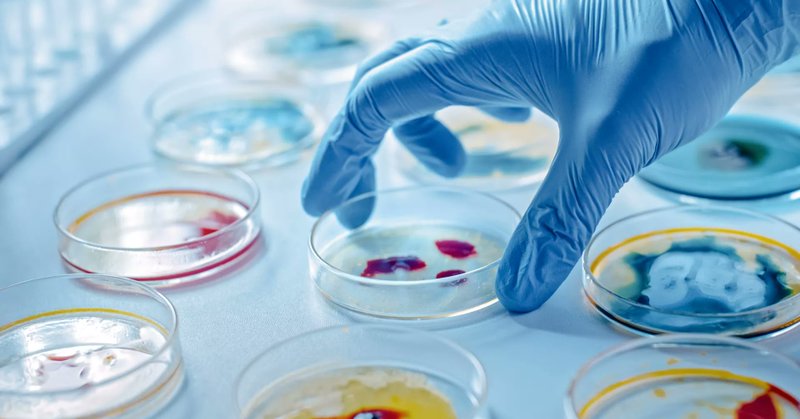
Tweet card summary image

Frontiers - Microbiology
@FrontMicrobiol
Followers
24K
Following
4K
Media
2K
Statuses
32K
Research and updates from all @FrontiersIn journals in the field of microbiology. #openaccess
Lausanne, Switzerland
Joined October 2011
Follow along for the latest research, updates and news from all @FrontiersIn journals in the field of microbiology 👀
1
8
26
New Research: The poly (A) polymerase pcnB modulates virulence and resistance in Klebsiella pneumoniae by differentially regulating chromosomal mRNA stability and plasmid copy number https://t.co/GS2q58bbsH
#FrontiersIn #Microbiology
frontiersin.org
Klebsiella pneumoniae is a leading cause of healthcare-associated infections, with emerging strains exhibiting both multidrug resistance and hypervirulence, ...
0
0
0
New Research: Association between infants’ serum levels of 26 metals and gut microbiota: a hospital-based cross-sectional study in China https://t.co/EhfDkexuhb
#FrontiersIn #Microbiology
frontiersin.org
BackgroundThis study examined the associations of toxic metals, essential metals, and rare earth elements with infant gut microbiota at Hunan Children’s Hosp...
0
2
1
New Research: Mechanisms of aerobic exercise effects on the gut microbiota and its metabolites in anxiety disorders https://t.co/xzcVtVzsZK
#FrontiersIn #Microbiology
frontiersin.org
Anxiety disorders are prevalent and disabling conditions that frequently co-occur with major depression, alcohol and substance abuse disorders, and personali...
0
0
1
New Research: Cryptic sulfur cycling in the deep biosphere of ferruginous Lake Towuti, Indonesia https://t.co/CLV2beZS1U
#FrontiersIn #Microbiology
frontiersin.org
Lake Towuti, Sulawesi, Indonesia is an ancient tectonic lake, exhibiting iron-rich, sulfate-poor anoxic deep waters. Temporal variations in water column stra...
0
0
2
New Research: Effect of IFN-τ on intestinal flora and metabolomics of Escherichia coli-mediated endometritis in mice https://t.co/n5WaqNeVLa
#FrontiersIn #Microbiology
frontiersin.org
Endometritis is a common reproductive disease in dairy cows, which can lead to low fertility or infertility and cause significant economic losses to the dair...
1
1
3
New Research: Effects of long-term biochar application combined with chemical fertilization on the nitrifier community in tobacco plantation soil https://t.co/YKB8bQRIQM
#FrontiersIn #Microbiology
frontiersin.org
Soil nitrogen (N) plays a critical role in plant nutrition and is regulated by the process of nitrification. Biochar can enhance soil N concentration and is ...
0
1
1
New Research: Trophic levels of decomposers in the treatment of herbicide wastewater: a mediator of positive interactions among microbial community assembly, function and stability https://t.co/bjMhG2oa76
#FrontiersIn #Microbiology
frontiersin.org
Current wastewater treatment methods tend to acclimate to sludge, but they may not be able to address the presence of herbicides with complex components in a...
0
1
4
New Research: Mucosal immune response modulated by secreted and membrane-bound hydrolases of Candida albicans in vulvovaginal candidiasis https://t.co/0JmnmGL5hB
#FrontiersIn #FungalBiology
frontiersin.org
Vulvovaginal candidiasis (VVC) affects the physical and mental health of millions of women worldwide. The leading cause of VVC, Candida albicans, can induce ...
0
1
2
New Research: Novel diversity of Anaerolineae and Tepidiformia recovered from metagenomes of thermal microbial mats in Costa Rica https://t.co/i8yhxHyOMX
#FrontiersIn #Microbiology
frontiersin.org
Tropical thermal and mineral springs are ideal for studying microbial life in extreme environments, their microbial diversity, and functional profiles. In th...
0
1
1
New Research: How straw returning impacts microbial-interaction-network-mediated improvements in soil multifunctionality https://t.co/hsox4ZmWA6
#FrontiersIn #Microbiology
frontiersin.org
IntroductionStraw returning is an important agricultural measure for improving soil health; however, the mechanism driving how it shapes the characteristics ...
0
2
5
New Research: Multidrug-resistant Gram-negative bacteria in lung transplantation: a narrative review of infectious complications and current management https://t.co/JARg3nLfO5
#FrontiersIn #Microbiology
frontiersin.org
Multidrug-resistant Gram-negative bacterial (MDR-GNB) infections represent a major challenge in lung transplantation (LuTx), due to their possible associatio...
1
4
6
New Research: Understanding gut microbial diversity using systems based on the Constrained-Disorder Principle provides a novel approach to targeting gut microbiome therapies https://t.co/dA3l2lXXoA
#FrontiersIn #Microbiology
frontiersin.org
Background/aimsThe diverse composition of the gut microbiome is vital for human health, influencing digestion, immune regulation, and disease resistance. Whi...
0
2
5
New Research: Biochemical, physicochemical property and archaea community characteristics in casing soil of cultivating Stropharia rugosoannulata https://t.co/tkybCDKvYw
#FrontiersIn #Microbiology
frontiersin.org
Mulching is very important in the cultivation of Stropharia rugosoannulata and helps in the formation of edible mushroom substrates. The physicochemical prop...
0
2
3
New Research: Prevalence, bacterial load, and genomic characterization of Vibrio parahaemolyticus in freshwater-farmed Litopenaeus vannamei from China https://t.co/UnHanJ9j9L
#FrontiersIn #Microbiology
frontiersin.org
Shrimp was the leading food vehicle for Vibrio parahaemolyticus outbreaks in China, yet studies on V. parahaemolyticus in globally predominant farmed shrimp ...
0
2
2
New Research: Efficacy and safety of probiotics as a complementary treatment for urticaria: a systematic review and meta-analysis https://t.co/L87KKzTkUM
#FrontiersIn #Microbiology
frontiersin.org
ObjectiveThe potential of probiotics in the treatment of urticaria has garnered significant attention. However, a systematic assessment of their benefits and...
0
2
3
New Research: Skewed pulmonary innate immune cell composition underlies the delayed influenza clearance in aged mice https://t.co/aNx2O1rqXq
#FrontiersIn #Microbiology
frontiersin.org
IntroductionAging increases vulnerability of the elderly to influenza, but the mechanisms have not been fully understood. Although lethally infected aged mic...
0
3
5
New Research: Integrating beneficial microorganisms and soil amendment for grapevine health: toward eco-friendly seasonal fungal disease management and soil improvement https://t.co/RPBlHfOmoG
#FrontiersIn #FungalBiology
frontiersin.org
This study evaluates the effectiveness of two biological agents, Trichoderma longibrachiatum and Pseudomonas yamanorum, together with compost addition. The r...
1
2
4
New Research: Soil phototroph community resilience comes from down under https://t.co/LDJZevLRts
#FrontiersIn #Microbiology
frontiersin.org
IntroductionSeed banks are widely recognized as means of recovery following disturbance across diverse ecosystems, including soil. Phototrophic microbes, whi...
0
2
2
New Research: Physiological stage-dependent effects of Mycobacterium tuberculosis on human placental tissue: insights into early reactivation and immune modulation https://t.co/oA47Xzr1tV
#FrontiersIn #Microbiology
frontiersin.org
BackgroundTuberculosis (TB) poses a significant risk during pregnancy and the postpartum period, with evidence linking these stages to an increased likelihoo...
0
2
6
New Research: Microbiota-mediated modulation of radiosensitivity: mechanisms and therapeutic prospects of oral and gut microbiota, metabolites, and probiotics https://t.co/6GWKFtRHLx
#FrontiersIn #Microbiology
frontiersin.org
Radiotherapy is a cornerstone of comprehensive cancer treatment, yet its efficacy and toxicity exhibit considerable interindividual variation. Recent evidenc...
0
2
5